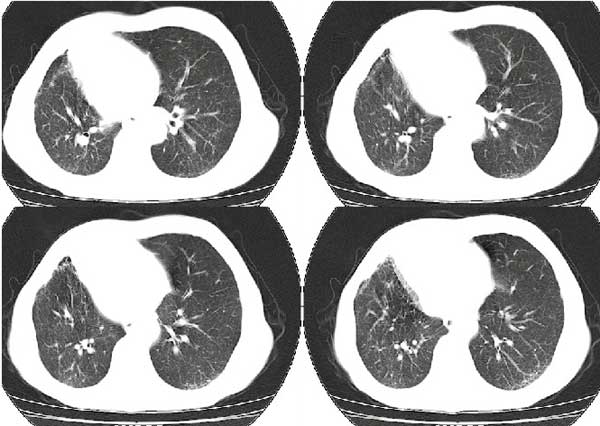

以下是引用扬仪在2005-5-12 20:46:40的发言:[br]右肺呈术后改变;双侧肺野散在分布斑片状、点状高密度病灶,(似可见“树芽征”);左上尖后段见斑团状高密度病灶(2个层面?),边缘毛糙,段性分布,与斜裂相邻,临近胸膜粘连;增强示病灶边缘强化,内呈水样密度;心影、纵隔右移,内可见4r淋巴结肿大。[br]意见:1、双肺继发性肺结核,左上为干酪病灶;[br] 2、矽肺合并感染;[br] 3、建议抗痨+抗炎。 [br]愚人之见,请高人指教!
以下是引用扬仪在2005-5-12 20:46:40的发言:[br]右肺呈术后改变;双侧肺野散在分布斑片状、点状高密度病灶,(似可见“树芽征”);左上尖后段见斑团状高密度病灶(2个层面?),边缘毛糙,段性分布,与斜裂相邻,临近胸膜粘连;增强示病灶边缘强化,内呈水样密度;心影、纵隔右移,内可见4r淋巴结肿大。[br]意见:1、双肺继发性肺结核,左上为干酪病灶;[br] 2、矽肺合并感染;[br] 3、建议抗痨+抗炎。 [br]愚人之见,请高人指教!
| 欢迎光临 医影在线 (http://bbs.radida.com/bbs/) | Powered by Discuz! X3.2 |